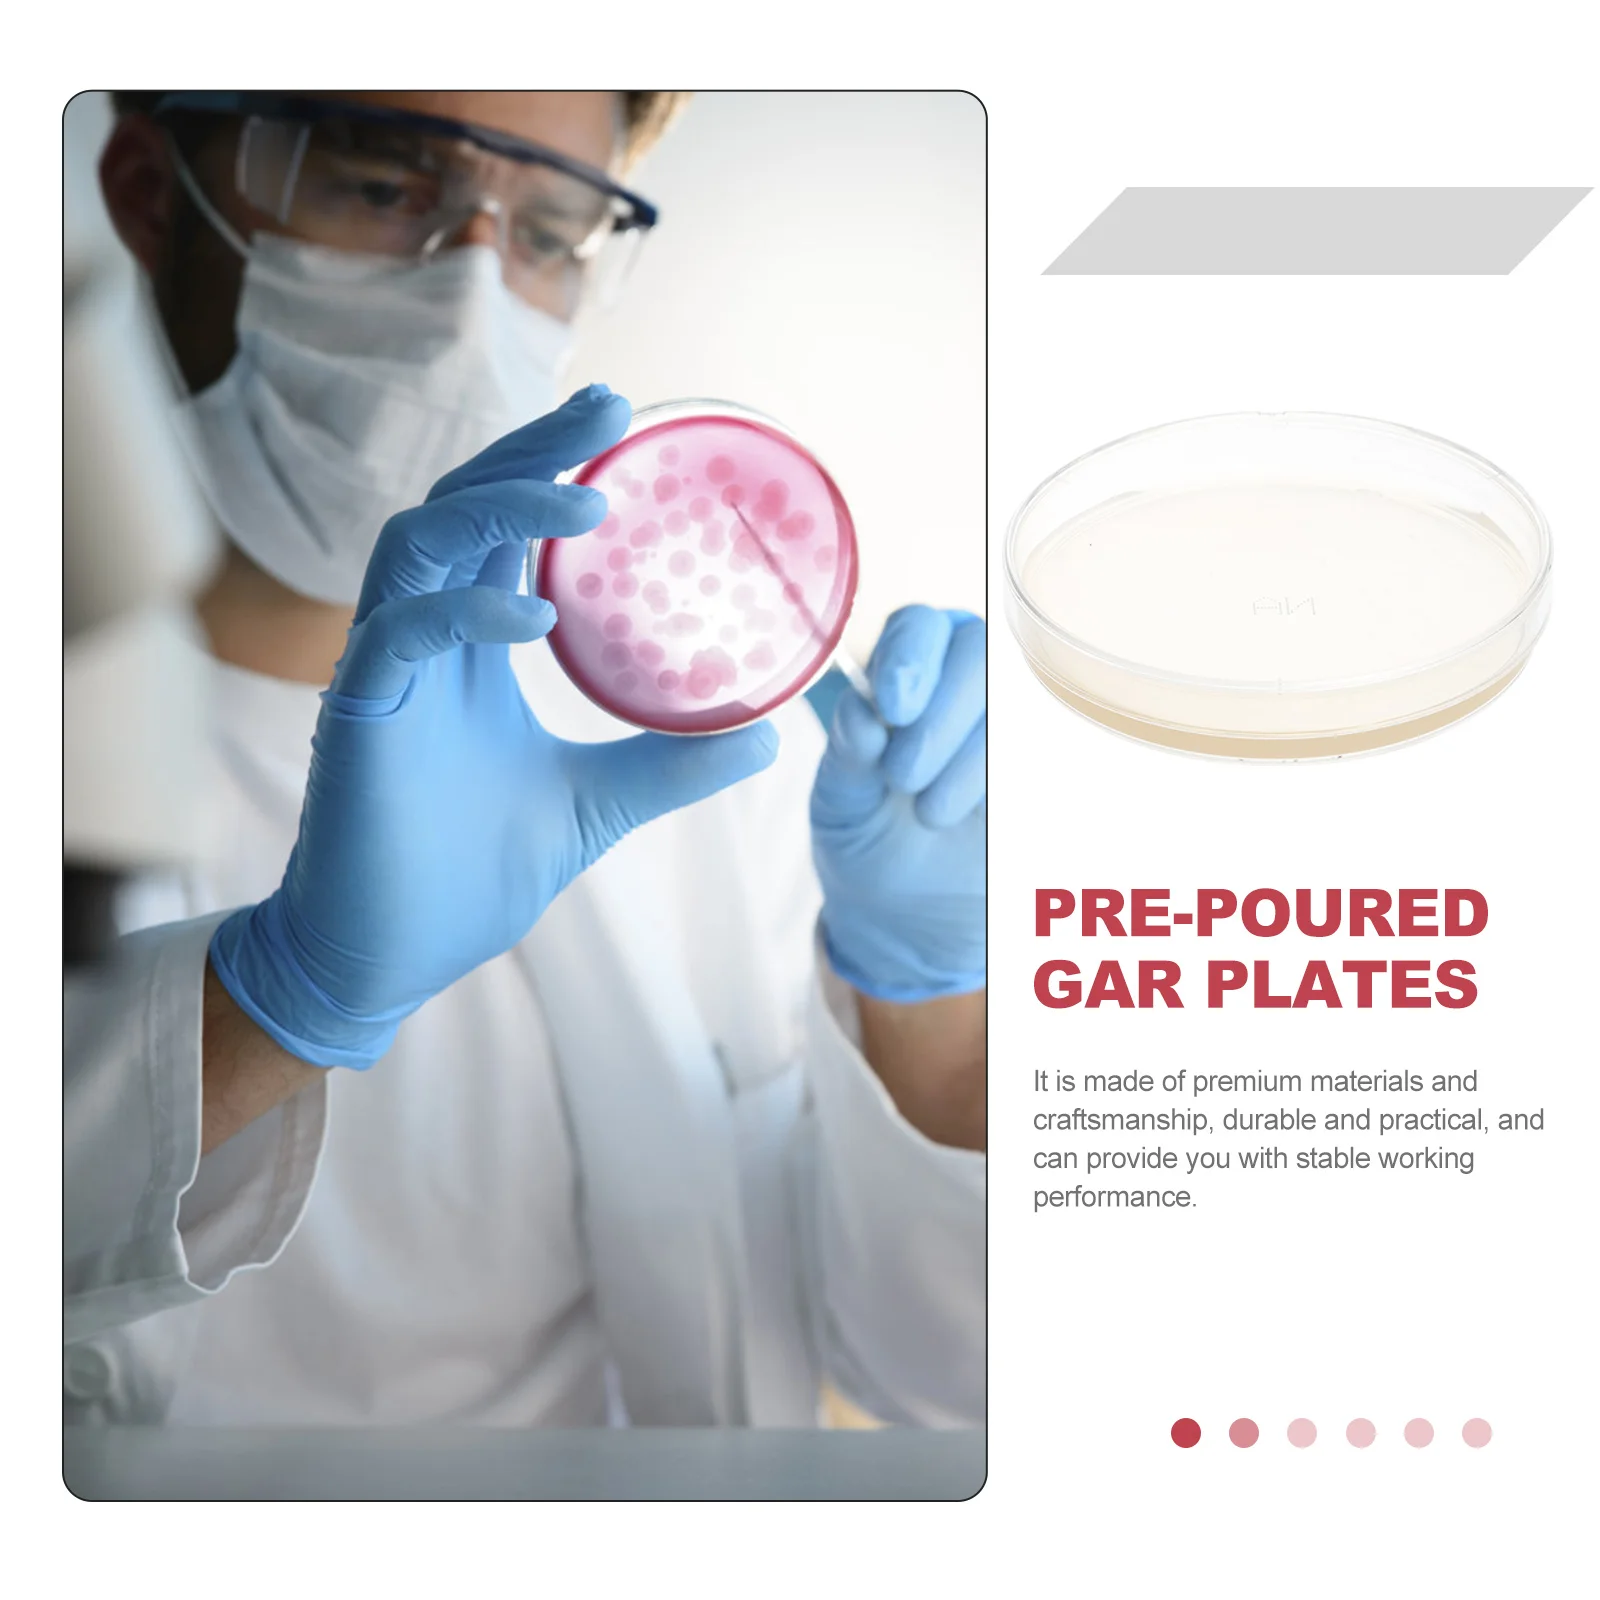

Agar Petri Dishes Plates Dish Plate Science Kit Poured Project Culture Fair Pre Tissue Kids Prepoured Sterile Nutrient Growing

sku: 1005005185694522
ACCORDING TO OUR RECORDS THIS PRODUCT IS NOT AVAILABLE NOW
$16.63
Shipping from: China
Price history chart & currency exchange rate
Customers also viewed

$278.92
Handheld Pneumatic Drilling Machine YO18 Mining Rock Drill Rock Crusher Tunnel Excavation
aliexpress.com
$84.06
Autotop CarPlay Android Auto AI Upgrade BOX for Highlander/RAV4/4Runner/Tundra/Tacoma/Camry/Corolla/Avalon/Prius/CH-R/Sienna
aliexpress.com
$7.00
Retro Electric Steam Train Track Toy Gift Box Set Simulation High Speed Train Rail Car Toy for Boy Girl
aliexpress.com
$3.54
5~50PCS 100% New Original 5.0V Power Supply Module AMS1117-5V Power Supply Module 1117-5.0
aliexpress.com
$3.49
Earplugs For Swimming Noise Reduction Waterproof Swimming Earplugs Reusable Water Ear Plugs With Lanyard Swim Accessories
aliexpress.com
$8.28
Pickleball Net Pickle Ball Net Lightweight Training Netting Pickle Ball Trainer for Home Outdoor Activities Beach Backyard
aliexpress.com
$79.07
Identity V Anne Lester Toy Dealers Cosplay Costume Cos Anime Game Roleplay Clothes Suits Hallowen Carnival Holiday Party Uniform
aliexpress.com
$29.99
Women Holiday Style Sexy Kniting Camisole Summer Short Tops Hand Crocheted Sweaters Flower Retro Ethnic Sweet Pulls Jumper B-072
aliexpress.com
$73.67
SignkoRay 150W Nema23 Integrated Servo Motor with Driver 36VDC 3N.m 1000rpm Servo Motor and Driver JSS57P3N
aliexpress.com
$31.23
Car Front Left Window Switch Lift Button Panel for BMW 6 Series GT G32 2017-2022 Door Armrests Panel Assembly LHD
aliexpress.com
$8.29
A95I-4Pcs Mini Chainsaw Chain 6 Inch Guide Saw Chain 1/4 LP Pitch, 37 Sections for Electric Portable Handheld Chain Saw
aliexpress.com
$0.71
Fluorescent Waterproof Face Tattoo Sticker Temporary Face Sticker For Halloween Music Concert Party Night Club Makeup Tattoos
aliexpress.com
$1.38
K8GE Tennis Vibration Dampener, Silicone Tennis Racket Shock Absorbers Tennis Racket String Shock Damping for Tennis Racquet
aliexpress.com
$16.74
Long-Lasting Performance High-Capacity Watch Battery For Apple Watch SE Watch SE 44mm
aliexpress.com
$17.30
Motorcycle Cam Timing Small Roller Chain For Kawasaki AN112 Britz R KLX125 KLX140 KLX140G KLX140L KLX150L OEM:92057-1449
aliexpress.com
$18.02
Chic Sexy vintage print Fairy Casual A-line Dress Vestido Summer dress Vacation Women Boho Sundress
aliexpress.com
$69.31
3X F4-04140000 Carburetor Assy For Parsun HDX Makara 4-Stroke F4 F5 BM 4Hp 5Hp Boat Outboard Motors
aliexpress.com
$7.87
Чехол для планшета BeCover Tri Fold Soft TPU Apple iPad Air 10.9 2020 Deep Blue (705503)
skidka.ua
$3.79
100pcs/Box Band Aid Bandage Hemostasis Adhessive Sticking Plaster Waterproof Breathable Medical Disposable First Aid C1301
aliexpress.com
$58.68
hugo boss 2021 new jacket men's color matching jacket hot style jacket cheap jacket running volume jacket jacket stand collar
fordeal.com
$50.70
Men's Jacket 2021 Spring Soft Fabric Embroidery Stars Flocking Printed High Street Windbreaker Zipper Baseball Coat Men Clothing
aliexpress.com
$15.76
Stainless steel scraper, glass glue scraper, edge trimming and joint filling tool, multifunctional scraper and hook knife
aliexpress.ru
$42.76
Leopard Jackets Tops Y2K Women Clothing 2024 Woman Autumn Trend Korean Style Vintage Elegant Coat Outerwears New Luxury Cropped
aliexpress.com
$333.70
9 inch Android 14 Touch Screen Stereo Radio Car Video DVD player for Ford transit 2015-2018 4G Wifi GPS Navigation Carplay
aliexpress.com
$33.30
New DW-AS-714-M30-002 DW-AS-701-M30-002 DW-AS-702-M30-002 DW-AS-703-M30-002 DW-AS-704-M30-002 DW-AS-713-M30-002 sensor
aliexpress.com
$52.28
361 Degrees AirWing Women Running Shoes Warmth Winter Cushioning Non-slip Rebound Comfortable Jogging Female Sneakers 682442210
aliexpress.com
$728.88
Wabi Sabi Italian minimalist marble coffee table combination round stainless steel tea table
aliexpress.com![custom. [Strong Bearing Capacity] Bathroom Toilet Storage Rack No Drilling Required Floor-Standing Bathroom Organizer New Style
custom. [Strong Bearing Capacity] Bathroom Toilet Storage Rack No Drilling Required Floor-Standing Bathroom Organizer New Style](http://ae-pic-a1.aliexpress-media.com/kf/Safa133b16b1c4177bf0c102bcbda0a73S.jpg)
$35.61
custom. [Strong Bearing Capacity] Bathroom Toilet Storage Rack No Drilling Required Floor-Standing Bathroom Organizer New Style
aliexpress.com






